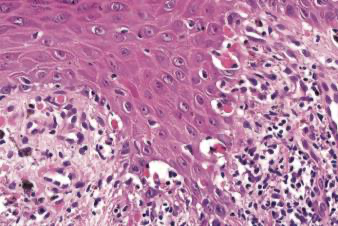
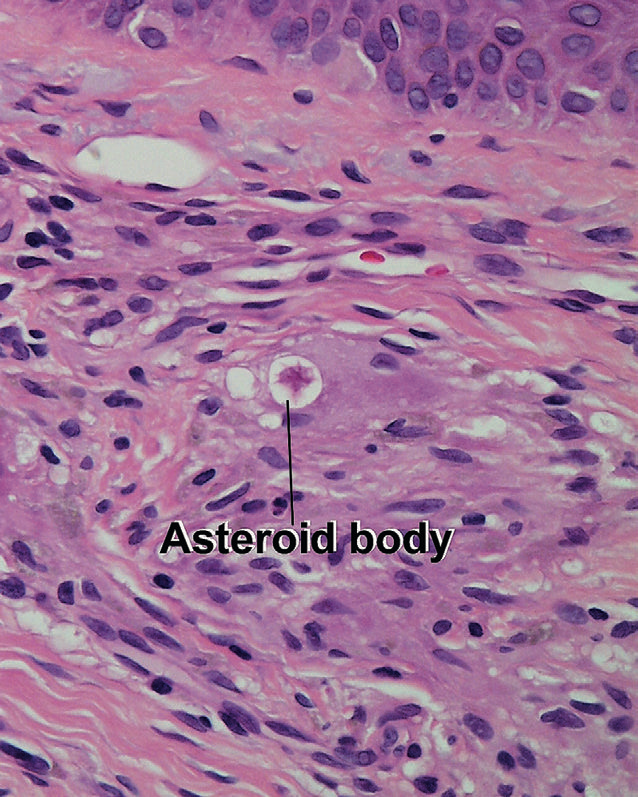

Langerhans Cells
- Marrow-derived, dendritic antigen presenting cells
- Clear cells in the suprabasal area
- Folded nucleus, no tonofilaments, desmosomes
- Contains Birbeck granules
- 2 to 4% of the epidermis
- Chronic and repeated exposures to UV depletes LCs
Stains for langerhans cells
- S100
- CD1a
- Langerin
Identify. What condition is this seen?

Max-Joseph Space
Lichen Planus
Identify. What condition is this seen?
Civatte Bodies
Lichen Planus
Loss of cell–cell adhesion

Acantholysis, pemphigus vulgaris

Anaplasia, Bowen’s disease
Atypical nuclei (abnormal size, shape, staining) and pleomorphism (variation in nuclear characteristics)
seen in?
sarcoidosis or berylliosis
- Collections of eosinophilic material seen in sporotrichosis
- Also refers to star-shaped intracytoplasmic inclusions seen in giant cells of sarcoidosis or berylliosis or other granulomatous processes
Caterpillar body - Pale pink linear basement membrane material within epidermis
Seen in?
porphyria cutanea tarda
- Represents degenerated type IV collagen

Dermatofibroma
Collagen fibers surrounded by histiocytes/spindle cells (collagen balls)

Corps ronds/grains, Darier’s disease
- Corps ronds = rounded nucleus with halo of pale to pink dyskeratotic cytoplasm
- Grain = dark blue flattened nucleus surrounded by minimal cytoplasm
- Dyskeratosis = abnormal, individual-cell keratinization

Cornoid lamellae, porokeratosis
45° angle parakeratosis in a column above a focus with a diminished granular layer and underlying dyskeratotic cells

Epidermotropism
Lymphocytes in epidermis with relative absence of spongiosis: term usually reserved for mycosis fungoides

Kamino body
Dull pink to amphophilic basement membrane material within the epidermis in a Spitz nevus

Medlar Body
- seen in Chromomycosis
- Brown, round structure resembling overlapping copper pennies
- Divide by septation, resembling a hot-cross bun

Pagetoid cells and pagetoid scatter, Paget’s disease

Papillary mesenchymal body
Structure that resembles the whorl of plump mesenchymal cells normally present in the hair papilla (seen in trichoblastoma and trichoepithelioma)

Shadow cells, pilomatricoma


